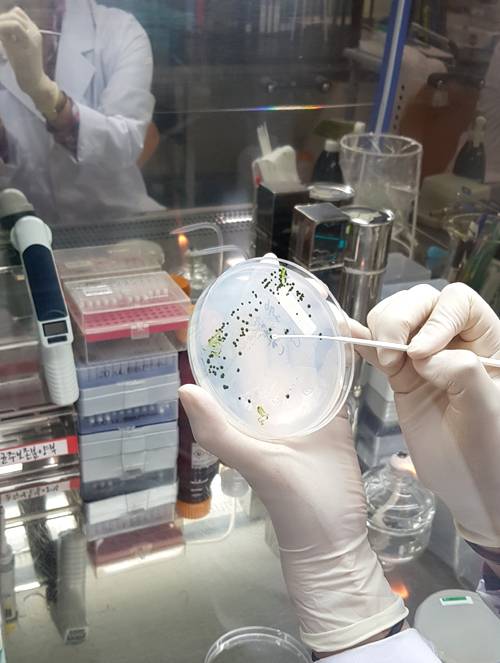

연료·환경보전 '두 토끼'..'녹조라떼' 미세조류의 재발견 [연중기획-지구의 미래]
|
|
| 세포 분리 국립낙동강생물자원관 연구원이 미세조류 세포 하나를 분리하고 있다. |
지난 1일 기자는 경북 상주시를 찾았다. 고속도로를 빠져나오자마자 커다란 곶감 조형물이 반기는 이곳에는 국립낙동강생물자원관이 있다. 우리나라에서 유일하게 담수생물자원을 전문적으로 연구하기 위해 낙동강을 바로 옆에 끼고 2015년 개원했다. 이 자원관에 마련된 담수 생물자원은행은 미세조류를 다량 보유하고 있다.
|
|
| 녹조 일으키는 ‘마이크로시스티스’ 국립낙동강생물자원관 담수조류배양실에 보관 중인 마이크로시스티스. |
미세조류가 30억년 넘게 ‘가계’를 이어올 수 있었던 건 뛰어난 적응력 덕이다. 미세조류는 펄펄 끓는 온천이나 빙하 아래, 여느 바다보다 몇 배나 짠 사해 등 온도, 염분, 산성도(pH)를 가리지 않고 거의 모든 곳에 포진해 있다. 그만큼 종류도 다양(약 5만 종 추정)하고, 극한 환경에서 살아남을 ‘비장의 무기’도 많다.
더구나 조건만 맞으면 왕성하게 번식하기 때문에 탄소배출이나 비료·물 사용 논란에서 자유롭지 못한 옥수수, 콩 등 여느 바이오산업 작물보다 환경 부담이 덜하다. 바로 이 점이 사람들이 미세조류에 눈을 돌린 이유다.
낙동강생물자원관에는 우리나라에 서식하는 미세조류 가운데 160여종 420주가 있다. 여기서 ‘주’란 조류가 사는 일종의 주소지를 말한다. 같은 종이라도 사는 곳이 서울이냐 부산이냐에 따라 약간의 차이가 있을 수 있어 이렇게 구분한다. 그래서 조류를 배양할 때는 순천만 국제습지센터, 수원 평지천, 길상사처럼 조류를 채수한 장소를 함께 적는다.
|
|
| 160여종 420주 보관 국립낙동강생물자원관 담수조류배양실. 미세조류 160여종 420주를 보관 중이다. |
미세먼지 입자 하나의 크기가 10㎛ 이하인데 미세조류도 그만큼이나 작다. 미세조류 세포 하나를 분리하는 건 공기 중에서 미세먼지 입자 하나를 콕 집아내는 것만큼이나 힘든 작업이다.
자원관 내 담수조류배양실에 들어가니 순수하게 분리된 각각의 미세조류들이 시험관에 담겨 대형마트 진열대 같은 곳에 정렬돼 있었다.
키우다 죽을 수 있어서 각 주마다 4개씩 복제해 보관하고, 두 달마다 배양시험관을 바꿔준다. 이를 계대배양이라 한다.
배양실에는 4대강 녹조의 주인공 마이크로시스티스(실은 녹조류가 아니고 남조류)도 있다. 그런데 시험관에 든 마이크로시스티스는 ‘녹조라떼’라는 악명에 걸맞지 않게 바닥에 희미하게 깔려 비실비실한 모습이었다.
김지환 자원관 균주보존분양부장은 “자연에서와 달리 실험실에서는 대량배양이 어렵다”며 “조류마다 최적의 온도, 일조시간이 있는데 조류배양실에서는 일괄적으로 온도와 일조시간을 설정하다보니 최적 생장조건을 맞추지 못하는 것”이라고 전했다.
자원관에서 기른 조류는 연구기관이나 기업에 무료 분양된다.


◆미세조류로 자원확보·환경 둘 다 잡을 수 있을까
세계 각국도 미세조류 기관을 운영 중이다. 미국 텍사스대 조류은행(UTEX)은 1953년 설립돼 3000여종의 조류를 보유하고 있다.
조류는 물에 살기 때문에 액체 배지(배양액)에 보관해야 한다. 조류마다 최적의 배지가 다르다. 갓 발걸음을 뗀 낙동강생물자원관은 배지가 6종류뿐인데 UTEX는 무려 90여 종류나 된다. 또 살아 있는 조류를 주기적으로 계대배양해야 하는 번거로움의 최소화를 위해 보유 종의 20%는 동결보존하고 있다. 조류는 얼렸다 해동하면 세포가 파괴되기 쉬워 우리나라에서는 아직 연구 단계에 머물러 있는 기술을 UTEX는 이미 상용화해 쓰고 있다.
일본 국립환경연구원(NIES)과 영국 조류·원생동물자원관(CCAP)도 각각 2700종, 2500종을 보존·관리 중이다.
조류는 35억년을 버틴 ‘생존의 귀재’답게 사람이 뽑아 쓸만한 유용한 재료가 많다. 클로렐라나 스피룰리나가 대표적이다.
스피룰리나는 60∼70%가 단백질로 이뤄졌는데 그 성분 중에 뇌손상 억제 및 항염증, 항알레르기 기능이 있어 활용 잠재력이 크다.
최근에는 조류를 이용한 ‘바이오 연료’ 연구도 활발하다. 장용근 한국과학기술원(KAIST) 교수(생명화학공학)도 그런 연구자 중 한 명이다. 그는 트라우스토키트리드라는 조류로 바이오 항공유를 만들고 있다.
미국과 네덜란드, 독일 등에서는 수년 전부터 바이오 항공유를 일정 비율 섞어 사용하고 있고, 우리나라 대한항공도 지난해 처음으로 옥수수 추출 기름을 5% 섞어 미 시카고∼인천 구간을 운항했다. 하지만 현재 주로 사용되는 바이오 항공유는 가격이 비싸다는 게 결정적 한계다.
|
|
| 별도 관리 중인 미세조류 실험에 필요한 미세조류는 별도로 관리된다. |
장 교수는 “지금까지 DHA는 고등어 같은 생선에서 주로 얻었지만, 어족자원 고갈과 중금속 축적 문제가 있다”며 “미세조류는 자기 무게의 25%까지도 DHA를 축적할 수 있어 매우 효율적이고 상업성 높은 자원”이라고 전했다.
즉 바이오 항공유만으로 가격경쟁력을 갖추기 어렵다면 재주는 바이오 항공유가 부리고 돈은 DHA로 버는 전략을 쓰겠다는 것이다. 미세조류 항공유에서 나오는 이산화탄소는 다시 미세조류를 키워 흡수할 수 있으므로 이론상 ‘탄소 순배출 제로’도 가능하다. 이 밖에 비타민 A∼E, 비오틴, 엽산, 판토텐산 등 거의 모든 종류의 비타민과 각종 항산화물질도 미세조류에서 찾을 수 있다.
오희목 한국생명공학연구원 책임연구원은 “미세조류를 잘 활용하면 자원확보와 환경 두 마리 토끼를 잡을 수 있다”며 “그간 연구결과를 상업화하기 위한 노력이 절실한 시점”이라고 강조했다.
지구온난화와 식량문제에 직면해 미래를 고민하는 인간에게 지구 생명체의 조상인 미세조류는 해법을 안겨줄 수 있을까.
상주=글·사진 윤지로 기자 kornyap@segye.com
Copyright © 세계일보. 무단전재 및 재배포 금지.
- 단칸방서 불판 닦던 ‘가장’ 주지훈, 159억 건물주 만든 ‘집념의 품격’
- 길 잃고 산 '금호동' 집 10배 대박…조현아의 남다른 '은행 3시간' 재테크
- 7남매 집 사주고, 아내 간병까지…태진아가 350억 건물을 매각하는 이유
- 가구 공장 임영웅, 간장 판매왕 이정은…수억 몸값 만든 ‘월급 30만원’
- “5만원의 비참함이 1000만원으로” 유재석이 세운 ‘봉투의 품격’
- “내가 입열면 한국 뒤집어져”…참치 팔던 박왕열, 어떻게 ‘마약왕’ 됐나 [사건 속으로]
- “법대·의대·사진작가·교수…” 박성훈·구교환·미미, 계급장 뗀 ‘이름값’
- “세균아 죽어라~ 콸콸”…변기에 소금, 뜨거운 물 부었다가 화장실만 망쳤다
- '명량' 권율·'슬빵' 박호산…마흔 앞두고 개명 택한 배우들의 신의 한 수
- “피곤해서 그런 줄 알았는데”…이미 진행중인 ‘침묵의 지방간’